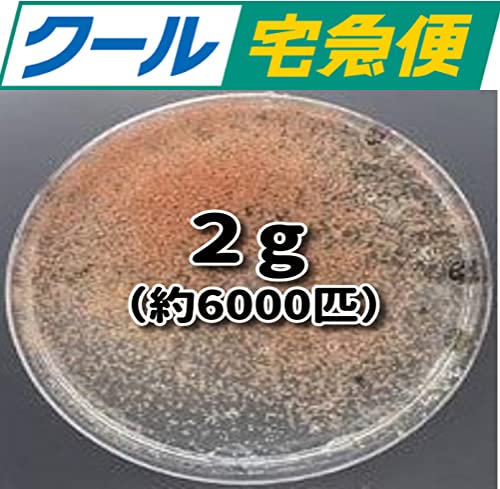
߂X ^}~WR  eO ߂  N ݂ (Qg N[ N1{t)

- タマミジンコ 生 (すべてのカテゴリ)
- 熱帯魚・アクアリウム用品
- 熱帯魚・アクアリウム用エサ
「タマミジンコ 生」の人気商品一覧 | 安い商品を通販サイトから探す
44件 1〜40件を表示- 価格の安い順
- 価格の高い順
- 検索条件:
- 熱帯魚・アクアリウム用エサ
- 本ページでは掲載するECサイトやメーカー等から購入実績などに基づいて手数料を受領しています。

熱帯魚・アクアリウム用エサ
- 楽天市場
-
(3)
称活きミジンコ内容量500〜1000匹(※販売時期によって増減することがあります。)仕 様100%タマミジンコではありません。採取の際にボウフラや赤虫などが混入します。天候や気温の関係上、ご入金完了から発送まで5営業日ほ

熱帯魚・アクアリウム用エサ
- 楽天市場
-
(81)
公式LINEにてメダカ飼育担当者のアフターケア付き

熱帯魚・アクアリウム用エサ
※本品は本州・四国の方限定販売商品となります。※《本州・四国限定》と記載された商品は、生体と「航空法第86条第1項」で定められた航空輸送ができない危険物(ガス、引火性液体、可燃性物質、酸化性物質等)を含んでいるため、航空

熱帯魚・アクアリウム用エサ
北半球に広く分布するミジンコの一種です。500〜800匹程度の生体を500mlのペットボトルに飼育水ごと入れて発送いたします。最大1.5mmほどのミジンコで比較的簡単に繁殖できるため観賞魚のエサとして人気があります。繁殖はメスのみで単為

熱帯魚・アクアリウム用エサ
- 楽天市場
-
(16)
北半球に広く分布するミジンコの一種です。500〜800匹程度の生体を500mlのペットボトルに飼育水ごと入れて発送いたします。最大1.5mmほどのミジンコで比較的簡単に繁殖できるため観賞魚のエサとして人気があります。繁殖はメスのみで単為

熱帯魚・アクアリウム用エサ
場合がございます。ご購入の前に、セット内容をよくご確認ください。タマミジンコを培養している飼育水を、500〜800匹程度のタマミジンコと一緒にお送り致します。※500ml

熱帯魚・アクアリウム用エサ
- 楽天市場
-
(4)
商品説明 タマミジンコが大部分になりますがケンミジンも混じりますのでご了承ください。1g=3,000匹と計算しております。。20g=60,000個体以上。(クロレラは入っていません)。 ミジンコはどん...

熱帯魚・アクアリウム用エサ
商品説明 タマミジンコが大部分になりますがケンミジンも混じりますのでご了承ください。1g=3,000匹と計算しております。。50g=150,000個体以上。 濃縮培養液500ml。20〜30倍希釈にて使用...

熱帯魚・アクアリウム用エサ
- 楽天市場
-
(4)
【タマミジンコ】 タマミジンコ は0.5〜1ミリ程度まで成長する小型のミジンコで、栄養価が高くめだか、らんちゅう、グッピー、ベタなど多くの観賞魚に最適な生餌です。 特に繁殖期の栄養補給に人気が高い生餌となります...

熱帯魚・アクアリウム用エサ
繁殖・隔離用品 ブライン・稚魚用餌 ブラインシュリンプ/孵化器 培養 培養セット 飼育 飼育セット 生餌 活餌 生き餌 活き餌 ミジンコ養魚 _hachu _aqua 生体 _kame fry_bait...

熱帯魚・アクアリウム用エサ
タマミジンコの乾燥休眠卵となります。1.5mlのマイクロチューブに休眠卵0.16g(鞘状卵約4万個=受精卵8万個)が入っています。通年ふ化させることが可能となっております。全ての卵が孵化するわけではありません...

熱帯魚・アクアリウム用エサ
場合がございます。ご購入の前に、セット内容をよくご確認ください。タマミジンコを培養している飼育水を、500〜800匹程度のタマミジンコと一緒にお送り致します。※500ml

熱帯魚・アクアリウム用エサ
北半球に広く分布するミジンコの一種です。500〜800匹程度の生体を500mlのペットボトルに飼育水ごと入れて発送いたします。最大1.5mmほどのミジンコで比較的簡単に繁殖できるため観賞魚のエサとして人気があります。繁殖はメスのみで単為

熱帯魚・アクアリウム用エサ
商品説明 タマミジンコが大部分になりますがケンミジンも混じりますのでご了承ください。1g=3,000匹と計算しております。。50g=150,000個体以上。(クロレラは入っていません)。 ミジンコはど...

熱帯魚・アクアリウム用エサ
北半球に広く分布するミジンコの一種です。500〜800匹程度の生体を500mlのペットボトルに飼育水ごと入れて発送いたします。最大1.5mmほどのミジンコで比較的簡単に繁殖できるため観賞魚のエサとして人気があります。繁殖はメスのみで単為

熱帯魚・アクアリウム用エサ
観賞魚に最適なタマミジンコ(生餌)タマミジンコ入り飼育水(500ml)1本+ff num900 プレミアム稚魚用フード 高タンパク育成フード パウダー 30g対象種稚魚・成魚(メダカ・ネオンテトラ)などセット内容...

熱帯魚・アクアリウム用エサ
繁殖・隔離用品 ブライン・稚魚用餌 ブラインシュリンプ/孵化器 培養 培養セット 飼育 飼育セット 生餌 活餌 生き餌 活き餌 ミジンコ養魚 _hachu _aqua 生体 _kame fry_bait...

熱帯魚・アクアリウム用エサ
- 楽天市場
-
(26)
【タイリクミジンコ】 体長は 最大4mmで60日前後の寿命があります。 メダカや金魚の餌として人気の タマミジンコの寿命が18日程度と比べると非常に寿命が長く飼育やすいのが特徴です。 栄養価が非常に高く めだか...

熱帯魚・アクアリウム用エサ
- 楽天市場
-
(4)
場合がございます。ご購入の前に、セット内容をよくご確認ください。タマミジンコを培養している飼育水を、500〜800匹程度のタマミジンコと一緒にお送り致します。※500ml

熱帯魚・アクアリウム用エサ
- 楽天市場
-
(57)
公式LINEにてメダカ飼育担当者のアフターケア付き

熱帯魚・アクアリウム用エサ
- 楽天市場
-
(1)
【タマミジンコ】 タマミジンコ は0.5〜1ミリ程度まで成長する小型のミジンコで、栄養価が高くめだか、らんちゅう、グッピー、ベタなど多くの観賞魚に最適な生餌です。 特に繁殖期の栄養補給に人気が高い生餌となります...

熱帯魚・アクアリウム用エサ
商品説明 名称 タマミジンコ 内容量 5g (1500匹) 備考 大阪市生野にあるメダカ専門店「メダカフレンド」で培養されたタマミジンコ5g(約15000匹)。簡易説明書を付属しておりますのでご確認ください...

熱帯魚・アクアリウム用エサ
場合がございます。ご購入の前に、セット内容をよくご確認ください。タマミジンコを培養している飼育水を、500〜800匹程度のタマミジンコと一緒にお送り致します。※500ml

熱帯魚・アクアリウム用エサ
- 楽天市場
-
(2)
濃縮培養液500ml。20〜30倍希釈にて使用。 当店で販売しておりますタマミジンコ・ワムシ用培養液2本セットです。 高栄養の生クロレラを主体にした専用の培養液です。 冷蔵庫にて保存して下さい。1ヶ月以内に使い切ってください...

熱帯魚・アクアリウム用エサ
- 楽天市場
-
(1)
タマミジンコの乾燥休眠卵となります。1.5mlのマイクロチューブに休眠卵0.16g(鞘状卵約4万個=受精卵8万個)が入っています。通年ふ化させることが可能となっております。全ての卵が孵化するわけではありません...

熱帯魚・アクアリウム用エサ
- 楽天市場
-
(20)
商品説明 タマミジンコが大部分になりますがケンミジンも混じりますのでご了承ください。1g=3,000匹と計算しております。。20g=60,000個体以上。 濃縮培養液500ml。20〜30倍希釈にて使用...

熱帯魚・アクアリウム用エサ
- 楽天市場
-
(6)
商品説明 名称 タマミジンコ 内容量 5g (1500匹) 備考 大阪市生野にあるメダカ専門店「メダカフレンド」で培養されたタマミジンコ5g(約15000匹)。簡易説明書を付属しておりますのでご確認ください...

熱帯魚・アクアリウム用エサ
- 楽天市場
-
(23)
商品説明 濃縮培養液500ml。20〜30倍希釈にて使用。 当店で販売しておりますタマミジンコ・ワムシ用培養液です。 高栄養の生クロレラを主体にした専用の培養液です。 冷蔵庫にて保存して下さい。1ヶ月以内に使い切ってください...

熱帯魚・アクアリウム用エサ
- 楽天市場
-
(28)
【オオミジンコ】 体長は 最大5mmで120日前後の寿命があります。 メダカや金魚の餌として人気の タマミジンコの寿命が18日程度と比べると非常に寿命が長く飼育やすいのが特徴です。 栄養価が非常に高く めだか...

熱帯魚・アクアリウム用エサ
- 楽天市場
-
(1)
商品情報名称タマミジンコ内容量約500匹 その他商品説明稚魚~成魚まで最高の生餌、メダカが喜びます。【発送について】観賞魚用ビニール袋に圧縮酸素を入れ袋を2重にし、それを発泡スチロールの箱にてお送りいたします...

熱帯魚・アクアリウム用エサ
- 楽天市場
-
(22)
タマミジンコ 400ml(100匹〜) 全長約1mmの古くから使用されている活餌です。 稚魚だけでなく様々な淡水魚が好んで食べます。 増殖させるには汲み置きの水を使用し、餌はイースト菌やほうれん草パウダーを使用します...

熱帯魚・アクアリウム用エサ
- 楽天市場
-
(45)
公式LINEにてメダカ飼育担当者のアフターケア付き

熱帯魚・アクアリウム用エサ
- 楽天市場
-
(23)
公式LINEにてメダカ飼育担当者のアフターケア付き

熱帯魚・アクアリウム用エサ
- 楽天市場
-
(1)
タマミジンコ 1000ml(約1000匹〜) 全長約1mmの古くから使用されている活餌です。 稚魚だけでなく様々な淡水魚が好んで食べます。 増殖させるには汲み置きの水を使用し、餌はイースト菌やほうれん草パウダーを使用します...

熱帯魚・アクアリウム用エサ
- 楽天市場
-
(22)
タマミジンコ 1000ml(250匹〜) 全長約1mmの古くから使用されている活餌です。 稚魚だけでなく様々な淡水魚が好んで食べます。 増殖させるには汲み置きの水を使用し、餌はイースト菌やほうれん草パウダーを使用します...

熱帯魚・アクアリウム用エサ
タマミジンコ耐久乾燥卵 ※約3万個入 卵から孵化させることで環境に合った個体が産まれる為、途絶えにくく、失敗が少なくなります。 餌の要求量が多い生き物ですので餌は途切れないよう与えて下さい。 【セット内容】...

熱帯魚・アクアリウム用エサ
- 楽天市場
-
(26)
【タマミジンコ】 タマミジンコ は0.5〜1ミリ程度まで成長する小型のミジンコで、栄養価が高くめだか、らんちゅう、グッピー、ベタなど多くの観賞魚に最適な生餌です。 特に繁殖期の栄養補給に人気が高い生餌となります...
熱帯魚・アクアリウム用エサカテゴリで検索されているキーワード:
お探しの商品はみつかりましたか?
検索条件の変更
ご利用前にお読み下さい
- ※ ご購入の前には必ずショップで最新情報をご確認下さい
- ※ 「掲載情報のご利用にあたって」を必ずご確認ください
- ※ 掲載している価格やスペック・付属品・画像など全ての情報は、万全の保証をいたしかねます。あらかじめご了承ください。
- ※ 各ショップの価格や在庫状況は常に変動しています。購入を検討する場合は、最新の情報を必ずご確認下さい。
- ※ ご購入の前には必ずショップのWebサイトで価格・利用規定等をご確認下さい。
- ※ 掲載しているスペック情報は万全な保証をいたしかねます。実際に購入を検討する場合は、必ず各メーカーへご確認ください。
- ※ ご購入の前にネット通販の注意点をご一読ください。
- ※ 本ページでは掲載するECサイトやメーカー等から購入実績などに基づいて手数料を受領しています。
- タマミジンコ 生
- 熱帯魚・アクアリウム用品
- 熱帯魚・アクアリウム用エサの通販情報・価格比較
- 価格.com
© Kakaku.com, Inc. All Rights Reserved. 無断転載禁止